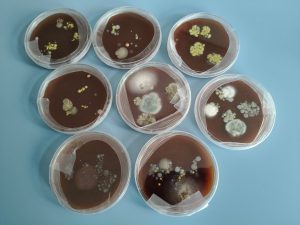

Si è concluso con entusiasmo il corso STEM del nostro Istituto Comprensivo, che ha visto protagoniste le alunne e gli alunni impegnati in un percorso coinvolgente e altamente formativo.
Sotto la guida del Prof. Roberto De Camillis, gli studenti hanno sperimentato attività di coding e robotica, partendo dall’assemblaggio dei robot fino ad arrivare alla loro programmazione e al controllo. A conclusione del percorso, i robot sono stati messi alla prova nell’aula di Informatica del plesso Schweitzer, dove si sono mossi seguendo schemi e comandi precisi, frutto del lavoro svolto durante il corso.
Particolarmente significativa è stata anche l’esperienza di uno degli incontri pomeridiani, interamente dedicato alla visita guidata presso il Centro Ricerche per gli Ecosistemi Marini e Pesca della sede di Termoli dell’Istituto Zooprofilattico Sperimentale (IZS) dell’Abruzzo e del Molise. In questa occasione, il personale scientifico specializzato in biologia marina e microbiologia ha offerto una dimostrazione concreta delle attività di monitoraggio e ricerca svolte per la tutela della salute umana in relazione all’ambiente.
Il corso ha rappresentato un’importante opportunità di crescita: ha permesso alle studentesse e agli studenti di approfondire le proprie conoscenze scientifiche, sviluppare il pensiero critico e potenziare le competenze digitali e di coding. Inoltre, il confronto diretto con professionisti del settore scientifico e tecnologico ha fornito preziosi spunti di riflessione, contribuendo ad accrescere la consapevolezza nelle scelte future, sia in ambito scolastico che, perché no, professionale.
Un sentito ringraziamento alla Direttrice, Dott.ssa Eliana Nerone, e a tutto il personale del Centro Ricerche dell’IZS di Termoli per la disponibilità, l’accoglienza e la preziosa collaborazione offerta ai nostri studenti.